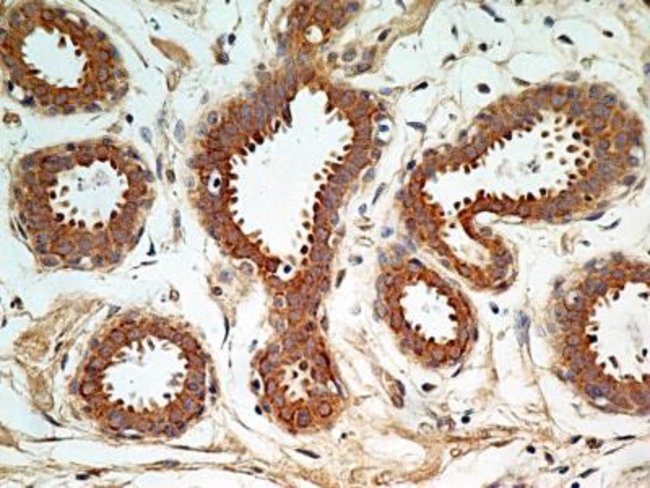

Anti-Pim1, Polyclonal, Rabbit Polyclonal Antibody, Each
$ 278.78
|
|
Details:
PIM1 Polyclonal specifically detects PIM1 in Human samples. It is validated for Western Blot, Immunohistochemistry, Immunocytochemistry/Immunofluorescence, Immunohistochemistry-Paraffin.
Additional Information
| SKU | 10153646 |
|---|---|
| UOM | Each |
| UNSPSC | 60104000 |
| Manufacturer Part Number | NBP231366SS |
